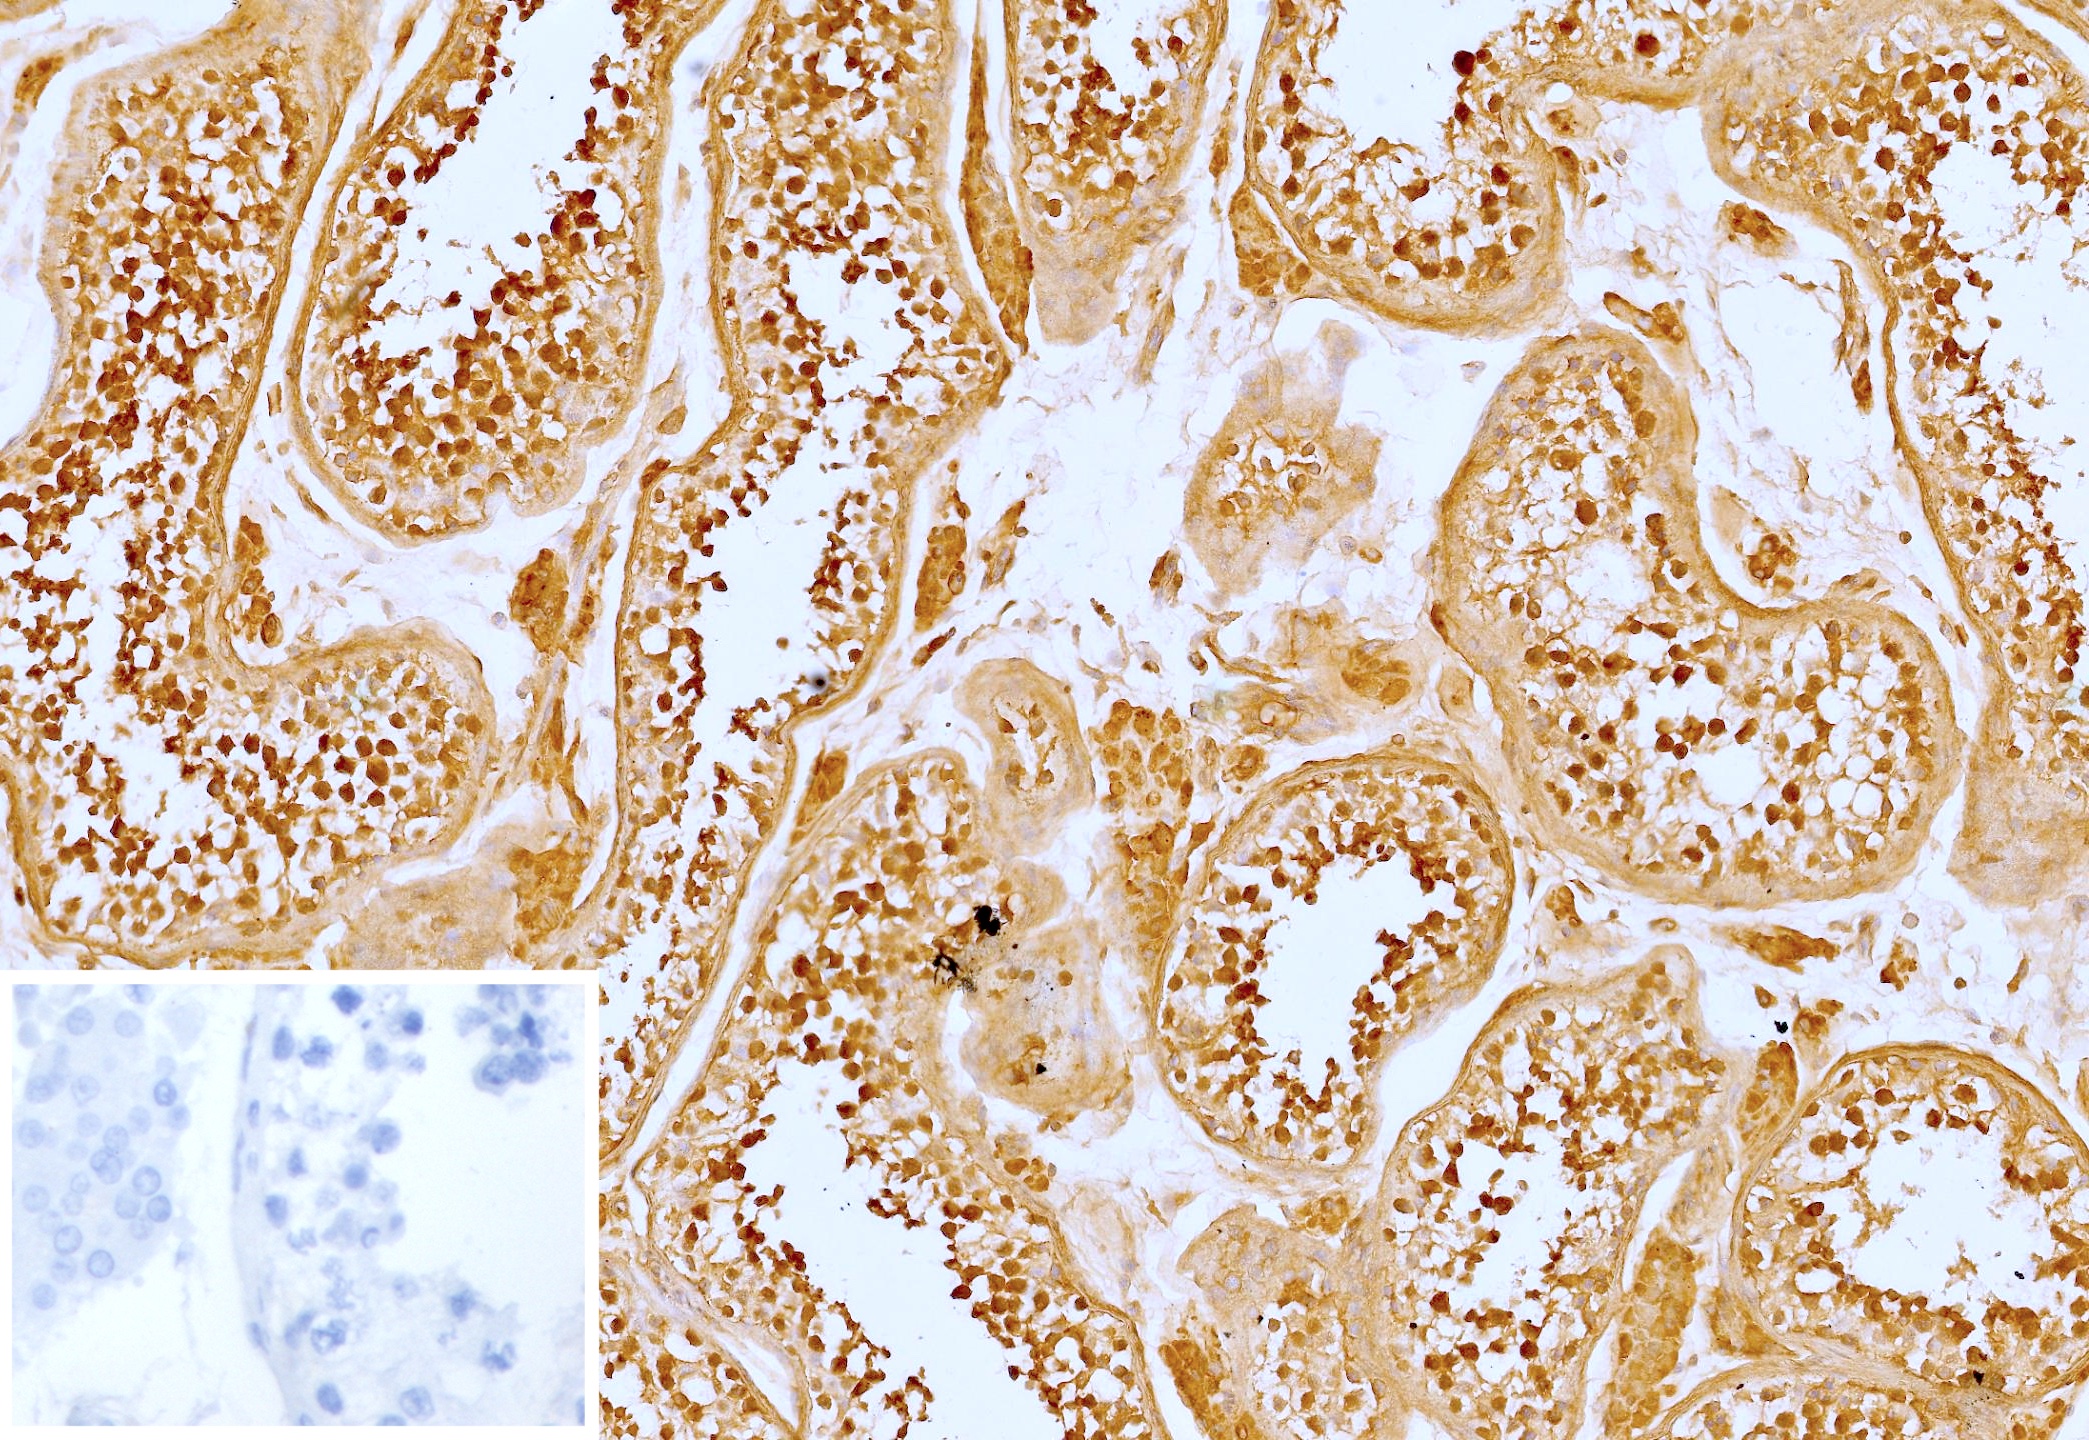

Formalin-fixed, paraffin-embedded human testis stained with VEGI Mouse Monoclonal Antibody (VEGI/13117). Inset: PBS instead of primary antibody; secondary only negative control.
VEGI is an anti-angiogenic cytokine that belongs to tumor necrosis factor superfamily, member 15 (TNFSF15). This protein is abundantly expressed in endothelial cells, but is not expressed in either B or T cells. The expression of this protein is inducible by TNF and IL-1 alpha. This cytokine is a ligand for receptor TNFRSF25 and decoy receptor TNFRSF21/DR6. It can activate NF-kappaB and MAP kinases, and acts as an autocrine factor to induce apoptosis in endothelial cells. This cytokine is also found to inhibit endothelial cell proliferation, and thus may function as an angiogenesis inhibitor. Reduced expression of VEGI has been reported as a marker of poor prognosis in breast cancer.
There are no reviews yet.